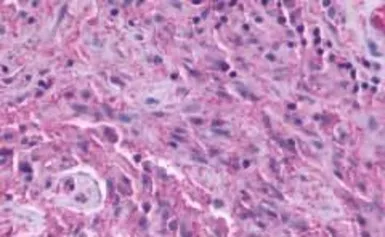

TM7SF1/GPR137B antibody
Cat. No. GTX71671
Cat. No. GTX71671
-
HostRabbit
-
ClonalityPolyclonal
-
IsotypeIgG
-
ApplicationsIHC-P
-
ReactivityHuman, Mouse, Rat, Rabbit, Bovine, Dog, Hamster, Pig, Monkey, Horse